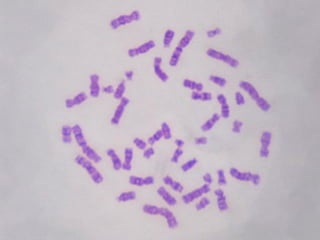

Este documento proporciona una introducción a la citogenética. Explica brevemente la historia de la citogenética, desde su inicio en 1882 hasta los avances actuales. También describe los componentes básicos de los cromosomas, como la estructura, composición y morfología. Finalmente, resume los principales métodos de estudio citogenético como el análisis de cariotipos y bandeo.